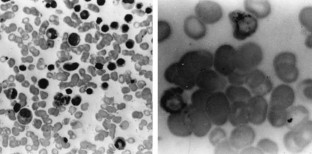

This is a preview of subscription content, access via your institution
Access options
Subscribe to this journal
Receive 12 print issues and online access
$259.00 per year
only $21.58 per issue
Buy this article
- Purchase on SpringerLink
- Instant access to the full article PDF.
USD 39.95
Prices may be subject to local taxes which are calculated during checkout
References
Park DJ, Koeffler HP . Therapy-related myelodysplastic syndromes Semin Hematol 1996 33: 256–273
Levine EG, Bloomfield CD . Leukemias and myelodysplastic syndromes secondary to drug, radiation and environmental exposure Semin Oncol 1992 19: 47–84
Pederson-Bjergaard J, Phillip P, Larsen SO, Andersson M, Daugaard G, Ersboll J, Hansen SW, Hou-Jensen K, Nielsen D, Sigsgaar DTC, Specht L, Osterlind K . Therapy-related myelodysplasia and acute myeloid leukemia: cytogenetic characteristics of 115 consecutive cases and risk in seven cohorts treated intensively for malignant diseases in the Copenhagen series Leukemia 1993 7: 1975–1986
Rosenbloom B, Schreck R, Koeffler HP . Therapy-related myelodysplastic syndromes Hematol Oncol Clin North Am 1992 6: 707–723
Sawyers CL . Chronic myeloid leukemia New Engl J Med 1999 340: 1330–1340
Faderl S, Talpaz M, Estrov Z, O'Brien S, Kurzrock R, Kantarjian HM . The biology of chronic myeloid leukemia New Engl J Med 1999 341: 164–172
Koc S, Harris JW . Sideroblastic anemia: variations on imprecision in diagnostic criteria, proposals for an extended classification of sideroblastic anemia Am J Hematol 1998 57: 1–6
Fernandez LA, Zayed E . Busulfan-induced sideroblastic anemia Am J Hematol 1988 28: 199–200
Acknowledgements
We are grateful to the Molecular Biology Laboratory of the State University of Campinas and CAC – Central de Análises Clínicas (Fortaleza – Ceará) for kind collaboration.
Author information
Authors and Affiliations
Rights and permissions
About this article
Cite this article
Magalhães, S., Duarte, F., Ribeiro, S. et al. Sideroblastic anemia following treatment of chronic myeloid leukemia with busulfan. Leukemia 14, 214–215 (2000). https://doi.org/10.1038/sj.leu.2401613
Received:
Accepted:
Published:
Issue date:
DOI: https://doi.org/10.1038/sj.leu.2401613